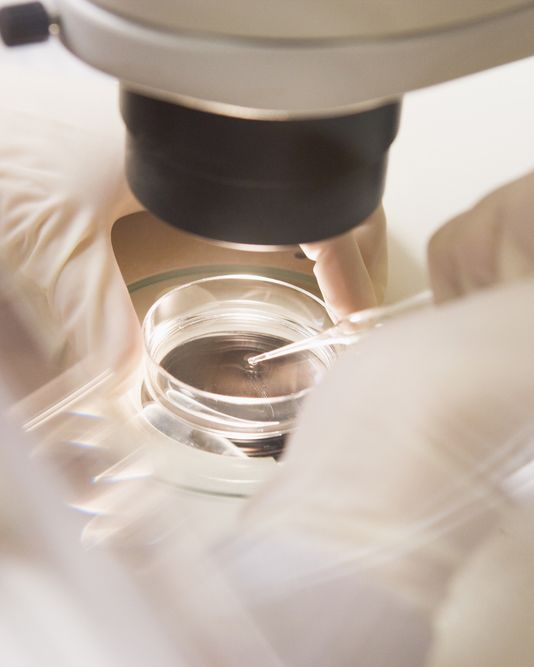
A lab technician with a microscope and petri dish

Egg Retrieval through Ultrasound-guided Aspiration
We perform technologically sophisticated, minimally invasive egg retrieval at our Los Angeles, CA practice as part of in vitro fertilization treatment. Many hopeful parents who have had difficulty conceiving have found success through IVF performed at the Center for Fertility and Gynecology.
The first step in an IVF cycle is ovulation induction, which involves the use of fertility medications to encourage the ovaries to produce multiple eggs. When the eggs have matured, a "trigger shot" is administered to stimulate their release from the follicles. Egg retrieval is the next step in the IVF process. If you would like to learn more about egg retrieval, or any of the other stages of the IVF procedure, please contact our office to schedule a consultation with Dr. Michael Vermesh or Dr. Tannaz Toloubeydokhti.
The Egg Retrieval Procedure
Our doctors employ a technique called ultrasound-guided needle aspiration to harvest the mature eggs at the appropriate time. This procedure is performed under anesthesia to ensure your comfort and safety. During your surgery, Dr. Vermesh or Dr. Toloubeydokhti will direct a needle, which is guided by ultrasound imaging, through the vagina and into the ovaries.
Once the ovaries have been accessed, the needle punctures the mature follicles and draws out the fluid and eggs. Our fertility specialists will then select the healthiest and most viable eggs to prepare for fertilization.
The entire procedure can typically be performed in under 30 minutes, and your doctor can retrieve multiple eggs during this stage of treatment. The retrieved eggs can be frozen and saved for future use, or prepared for fertilization in our laboratory. A few days after the egg retrieval procedure, patients will return to our office for the embryo transfer portion of the IVF process, or the embryos are frozen for future use.
After Your Egg Retrieval Surgery
Most patients do not have any significant pain following their procedure, and only experience minor discomfort that can be managed with over-the-counter pain relievers. Dr. Vermesh or Dr. Toloubeydokhti may prescribe additional pain medications to ensure your comfort. You will also be given a series of medications that will prevent infection and reduce inflammation to promote a faster recovery. Your doctor may also prescribe hormone supplements that will support the endometrial lining following the procedure. Patients generally do not require any significant downtime after the procedure, and can typically return to their normal routines later that day.
Schedule an IVF Consultation
if you have had difficulties conceiving and would like to learn more about IVF or any other ART procedure, please contact our offices in Tarzana, Bakersfield, Thousand Oaks, and Torrance for an appointment with Dr. Vermesh or Dr. Toloubeydokhti. We look forward to the opportunity to use the most sophisticated treatments available to help you experience parenthood.






